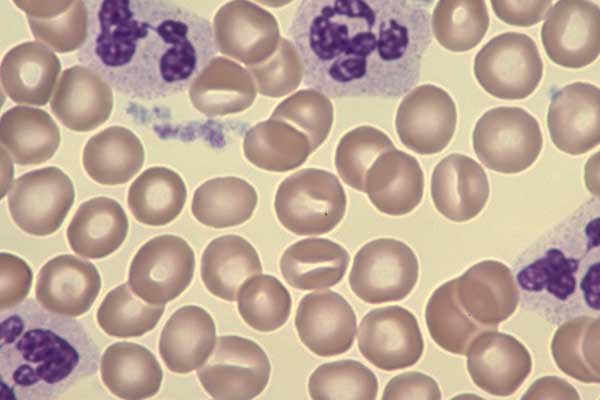

тропения 1
Нейтропения 1 116 фотографий
Храм в рубцово
До скольки играют в бильярд
Стрижка женская для 30 лет
Как менялся рост людей
Как выставить трамблер нива
Лагерь под пензой
Tecsun pl330
Устанавливаем ящики в шкаф
Шапочки для бассейна в москве
Какого года левандовски